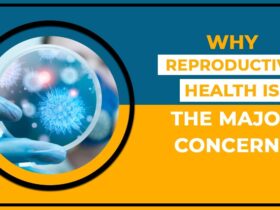

Tags
5g
AAA
Amazon
Amazon Web Services
Android
Apple
Artemis
Astronaut
audio
AWS
Bluetooth
CES
CES 2018
CES 2019
CES 2023
CES 2024
CES 2026
EV
Gaming
Headphones
International Space Station
iOS
iPhone
ISS
Kickstarter
LG
Mars
NASA
Nintendo
Nintendo Switch
PC Gaming
Playstation
RPG
samsung
Smartphone
Space
Space Station
SpaceX
Steam
T-Mobile
Thermaltake
TMobile
Toyota
Ubisoft
Xbox